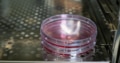
next-article-image

細胞培養で使用される足場材の特徴。プレコートプレートで円滑な細胞培養を実現

細胞培養の効率や成果は、使用する“足場材”の選択によって左右されます。適切な足場材を選ぶことで、細胞の接着や増殖を円滑に進めることが可能です。
この記事では、細胞培養において重要な役割を果たす“足場材”について、その種類や特徴、そして近年注目されているプレコートプレートの利点まで基礎から応用まで解説します。
細胞培養の基材についてはこちらの記事をご確認ください。
マイクロプレートの『サンプル』の取り寄せについてはこちらからお問い合わせください。
細胞培養で使用される足場材とは
細胞培養における足場材とは、細胞が培養容器内で適切に付着・増殖・分化できるようにサポートする材料のことです。
生体内では細胞は細胞外マトリックス(ECM)と呼ばれる構造に支えられていますが、体外での培養ではこの役割を人工的な足場材が担います。
足場材は、細胞の種類や目的に応じて選択され、細胞の生存率や機能維持、増殖効率に大きな影響を与えます。
主にタンパク質由来の天然素材や、合成高分子、不織布、メッシュ、スポンジ状のものなど多様な種類が存在し、それぞれに特徴を持っています。足場材の選択は、再生医療や組織工学、創薬研究など、さまざまな分野で重要なポイントになります。
細胞培養におけるコーティングについてはこちらの記事で解説しています。
主な足場材の特徴
細胞培養でよく使用される足場材には、ラミニン、フィブロネクチン、ビトロネクチン、コラーゲンなどのタンパク質系素材が挙げられます。
これらは生体内の細胞外マトリックス成分としても存在し、細胞の接着や増殖、分化を促進する働きを担っています。
さらに、近年では合成高分子や不織布、メッシュ状の足場材も開発されており、細胞の大量培養や三次元培養にも対応できるようになりました。
足場材の選択は、目的とする細胞種や培養方法、求められる機能性によって異なります。
▼足場材の特徴
足場材 | 主な用途 | 特徴 |
ラミニン | 神経細胞、幹細胞 | 細胞接着・分化促進 |
フィブロネクチン | 多様な細胞種 | 細胞増殖・接着促進 |
ビトロネクチン | 未分化細胞 | 未分化維持・増殖促進 |
コラーゲン | 組織工学、3D培養 | 生体適合性・構造支持 |
ラミニン
ラミニンは、細胞外マトリックスの主要な構成成分の一つであり、特に神経細胞や幹細胞の培養において重要な役割を果たします。
細胞の接着や分化を促進するシグナルを与え、細胞の生存率や機能維持に寄与します。
また、神経細胞の伸長や分化誘導、幹細胞の未分化状態の維持など、特定の細胞種に対して高い効果が期待できるため、再生医療や神経科学の分野で広く用いられています。
ラミニンをコーティングした培養プレートは、細胞の均一な分布や高い生着率を実現できる点が大きな特徴です。
フィブロネクチン
フィブロネクチンは、細胞外マトリックスに存在する多機能な糖タンパク質で、さまざまな細胞種の接着や増殖をサポートします。
特に線維芽細胞や上皮細胞、内皮細胞など幅広い細胞に対して有効性が認められており、細胞の形態維持や移動、分化にも関与しています。
フィブロネクチンを用いた足場材は、細胞の均一な接着や増殖を促進し、組織工学や創薬研究など多様な用途で活用されています。また、フィブロネクチンは他の足場材と組み合わせて使用されることも多く、細胞培養の柔軟性を高める素材として注目を集めています。
ビトロネクチン
ビトロネクチンは、細胞外マトリックスの構成成分であり、特に未分化細胞や幹細胞の培養に適した足場材です。
細胞の接着や増殖を促進するだけでなく、未分化状態の維持にも寄与するため、iPS細胞やES細胞の培養に多用されています。
そのため、ビトロネクチンをコーティングしたプレートは、細胞の均一な分布や高い生存率を実現できるため、再生医療や細胞治療の研究現場で重宝されています。
コラーゲン
コラーゲンは、動物の結合組織に豊富に存在するタンパク質で、細胞培養において最も一般的に使用される足場材の一つです。
高い生体適合性と生分解性を持ち、細胞の接着や増殖、分化を強力にサポートするのが大きな特徴です。特に3D培養や組織工学の分野で多用されており、細胞が自然な形態で成長できる環境を提供します。
コラーゲンゲルやスポンジ、膜状など多様な形態で利用できるため、目的に応じた柔軟な培養が可能です。
円滑な細胞培養を実現するプレコートプレート
プレコートプレートとは、あらかじめ足場材がコーティングされた培養プレートのことを指します。従来、研究者自身が足場材をプレートに塗布する手間がありましたが、プレコートプレートを利用することで、作業の効率化と再現性の向上が可能となりました。
特に、ラミニンやフィブロネクチン、ビトロネクチン、コラーゲンなどの足場材が均一にコーティングされているため、細胞の接着や増殖が安定し、実験結果のばらつきを抑えることができます。
また、プレコートプレートは細胞種や目的に応じて最適な足場材が選択できるラインナップが揃っており、再生医療や創薬、基礎研究など幅広い分野で活用されています。品質管理が徹底されているため、細胞培養の信頼性も高まります。
具体的には以下のメリットが挙げられます。
作業工程の短縮と効率化
足場材の均一なコーティングによる再現性向上
細胞種や目的に応じた多様な製品展開
品質管理による信頼性の確保
▼従来との比較
項目 | 従来プレート | プレコートプレート |
足場材の塗布 | 手作業で必要 | 不要(工場でコーティング済み) |
作業時間 | 長い | 短縮による効率化が可能 |
再現性 | ばらつきが出やすい | 高い |
品質管理 | 個人差あり | 一貫した品質 |
日本ゼオンでは、高い接着性を持つ足場材がコーティング済みで、開封後すぐに使用できるReady-to-use のプレコートプレート「CELLAZIP™ 細胞培養用オリジナルコートプレート」を提供しています。
クリーニング試験や細胞観察、がん・神経・細胞治療研究など、幅広い分野で活用できる培養器材として高い透明性と生体適合性を持つシクロオレフィンポリマー素材に、アニマルフリー原料由来のコート剤を採用しているため、動物由来成分を避けたい研究環境にも最適。
アニマルフリーな培養環境を実現しつつ、薬物スクリーニングやハイコンテントスクリーニング、さらに高度な細胞観察まで、再現性の高い実験をサポートする器材としてご活用いただけます。
まとめ
この記事では、細胞培養で使用される足場材の特徴として以下を解説しました。
細胞培養で使用される足場材とは
主な足場材の特徴
円滑な細胞培養を実現するプレコートプレート
プレコートプレートを使用することで、品質の担保や作業時間の短縮など、円滑な細胞培養を実現できます。
日本ゼオンでは、シクロオレフィンポリマーを使用した高精度なイメージングに適したマイクロプレート『Aurora Microplates™』や細胞培養用オリジナルコートプレートを提供しています。
詳しくは、こちらの資料をご確認ください。